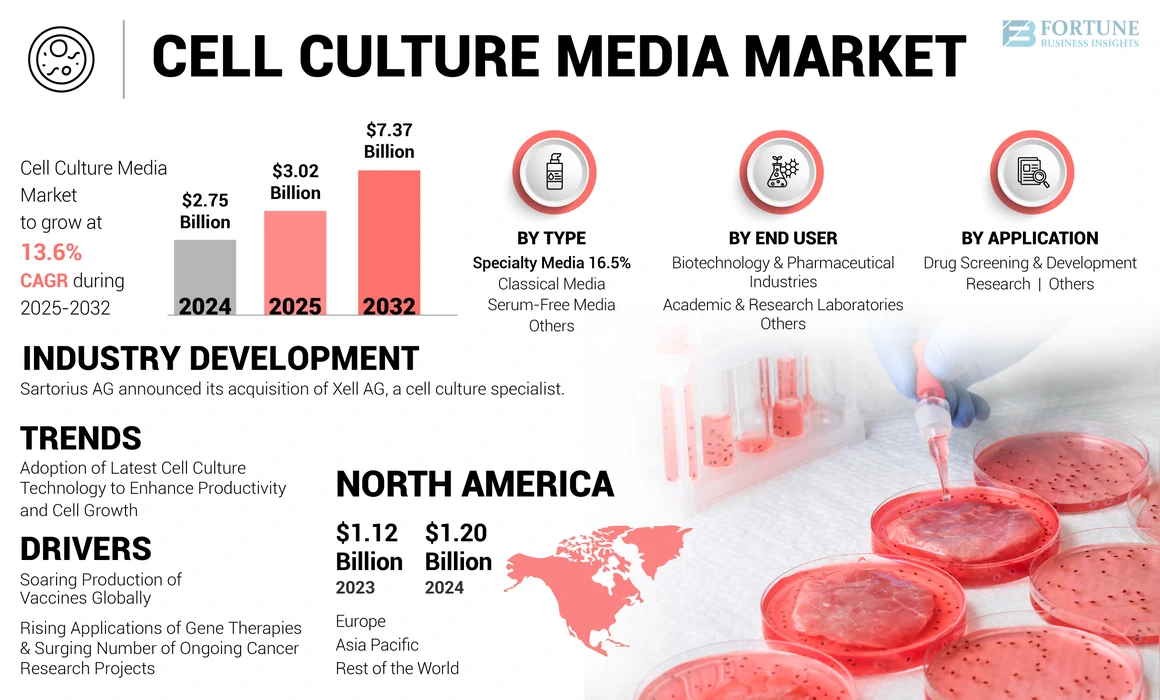
Cell Culture Media Market

"Designing Growth Strategies is in our DNA"
The global cell culture media market size was USD 2.75 billion in 2024. The market is projected to grow from USD 3.02 billion in 2025 to USD 7.37 billion by 2032, exhibiting a CAGR of 13.6% during the forecast period. North America dominated the global market with a share of 43.75% in 2023. Moreover, the U.S. cell culture media market size is projected to grow significantly, reaching an estimated value of USD 2.96 billion by 2032, driven by growing demand for vaccines due to increasing prevalence of infectious diseases.
Cell culture media constitutes solid, liquid, or semisolid media, which is made up of several contents and nutrients to simulate the growth, propagation, maintenance, and storage of microorganisms.
These products are one of the critical ingredients in biopharmaceutical manufacturing, therefore driving its demand and augmenting market growth. Furthermore, increasing expenditure by pharmaceutical companies to conduct R&D initiatives and emerging research initiatives to introduce cell-based vaccines is also set to drive the growth of the market.
Furthermore, the rising awareness regarding stem cell research and the growing focus of major companies to launch personalized and regenerative medicine augments the growth of the market. The COVID-19 pandemic positively impacted the demand for cell culture media. The pandemic led to an increase in the demand for these products for the production of vaccines. As the demand for vaccines rose during the period, production facilities started to expand in 2020. The demand for products such as vaccines remained high, augmenting the market size in 2021. The increase in research and development activities for developing different biologics and vaccines continued to lead to a rise in the demand for cell culture media. The market is anticipated to continue growing during the forecast period.
Adoption of the Latest Cell Culture Technology to Improve Cell Growth and Productivity
Researchers across the globe are conducting research and development activities to introduce new technologies to increase the efficiency of cell culture media for various clinical applications.
It has been witnessed that albumins are essential during the bio-manufacturing of therapeutic monoclonal antibodies and recombinant proteins. Albumin binds and stabilizes a range of important small molecules and ions.
Therefore, the addition of recombinant mammalian albumin supplement is expected to boost market growth and the product yield of cells in the culture medium by providing a synergistic effect in culturing Hybridoma and Chinese Hamster Ovary (CHO) cell lines.
Similarly, another advancement in the development of cell culture media is adding nano fibers. These fibers are optically transparent, which allows live-cell imaging and real-time quantification of cell mobility. The nano fibers also mimic the 3D topography in vivo and provide the potential to be easily coated with ECM proteins for cancer research.
Furthermore, the launches of instruments for easier and convenient analysis of drug products and media propels the market growth.
The adoption of these technology boosts the growth of the market in the forecast period.
Download Free sample to learn more about this report.
Increasing Research and Development for the Production of Vaccines Globally to Drive the Market Growth
Major pharmaceutical companies across the globe have started expanding their vaccine production facilities. New players are also seen to have entered the market. This has led to the expansion of vaccine production across all major countries. Due to these factors, the demand for raw materials such as culture media is also anticipated to grow, subsequently driving the global market growth.
Furthermore, the COVID-19 pandemic highlighted the importance of the production of vaccines across the globe. Thus, in order to meet the increasing demand for COVID-19 vaccines among people, many countries started producing their own vaccines.
In order to expand the production capacity of vaccines, cell cultures have also proven to be the most appropriate hosts for the propagation of many types of viruses. Thus, cell culture systems producing a large quantity of attenuated viral particles have always been the basis for the production of both bovine and human vaccines.
Furthermore, major players in the market have also engaged in the development of specialty media for maximum production and growth of the virus.
Cell lines derived from kidneys, such as Vero, MDCK, and HEK293, are currently used for the production of viral vaccines. Thus, the importance of these consumables in the production of vaccines and the increasing production capacity of vaccines are likely to augment the demand for these products during the forecast period.
Increasing Applications of Gene Therapies and Growing Number of Ongoing Cancer Research Projects to Boost the Product Demand
Gene therapy is used for the treatment of multiple acquired and inherited neurological diseases. In addition to this, gene products are also said to reduce cellular dysfunction and have been proven to be a new therapeutic option. Furthermore, several applications of gene therapy have currently emerged and researchers across the globe are involved in R&D activities to discover new applications.
Gene therapy is dependent upon viral vectors, which are used to deliver desirable genetic sequences into the cells of the targeted tissue. Propagation of viral vectors in the host cell is necessary for its clinical uses. Cell culture media which fulfills cellular requirements with recombinant proteins also reduces the introduction of viral RNA and DNA, prion proteins, undefined antigenic molecules, and others.
Furthermore, with the increased prevalence of chronic diseases such as cancer, research institutes have been carrying out several research projects to develop and launch new and advanced treatment options.
To carry out such projects, these products are widely used. Therefore, the growing number of research projects is anticipated to increase the demand for consumables, which supports the market growth.
Insufficient Infrastructure and Shortage of Highly Skilled Professionals in Emerging Nations Pose Obstacles to Market Growth
The preparation of cell culture media requires laboratories with modern and specifically designed equipment for sterilization and propagation purposes. However, in low and middle-income countries, laboratories are only equipped with basic instruments and have a poorly implemented quality management system with lack of resources, hindering the quality of culture media mainly due to the high contamination rate.
Moreover, the shortage of skilled personnel in culture laboratories further hampers the productivity. Emerging countries struggle to attract highly trained technicians, which impacts the preparation and maintenance of culture media and disrupts the entire process cycle. Additionally, developing countries, including those in Africa, have recorded significantly low investments in research and development, which also hinders the growth and development of laboratory infrastructure.
The above mentioned factors, along with ethical concerns with the adoption of animal-derived components, are anticipated to hinder market growth.
Rising Exploration in Genetic Engineering and Research Endeavors Fuel the Demand for Classical Media
On the basis of type, the market is subdivided into classical media, specialty media, serum free media, and others. The classical media segment accounted for the largest share of the market in 2024. The increasing research spending for biopharmaceutical and biotechnology products which require consumables such as cell culture media boosts the demand for these products.
The specialty media segment is expected to witness significant growth during the forecast period. Due to surge in the number of infectious diseases, the demand for specialty media for effective diagnosis of infectious microorganisms fuels the demand for specialty media.
The advantage of serum-free media over other media, such as increased growth or productivity and decreased contamination risk from serum-borne adventitious agents in cell culture, drives the demand for the segment. Furthermore, increasing launches of the serum free-media by key market players boosts the growth of the segment. For instance, in May 2023, Lonza launched the TheraPEAK T-VIVO Cell Culture Medium to optimize CAR T-cell manufacturing. The medium is free from animal-origin components, simplifies regulatory approval, and accelerates cell therapy development.
To know how our report can help streamline your business, Speak to Analyst
Adoption of Advanced 3D Models in Drug Development to Spur the Segment Growth
By application, the market is segregated into drug screening and development, research, and others.
The drug screening and development segment held a considerable market share in 2023. The increasing demand for culture media in the development of vaccines and several other therapeutic treatments has led major companies to introduce new products in the market, leading to the growth of the segment. Additionally, research initiatives for the launch of new technologically advanced cell culture platforms, such as 3D cell culture models for drug screening, also leads to the growth of the segment.
Such advancements propel the growth of the segment.
The research segment is expected to grow with a significant CAGR over the forecast period. Factors such as increasing R&D procedures for the development of new treatments for cancer augment the demand for cell culture media, driving the segmental growth. Other applications of these products include industrial production, diagnostics, and stem cell research. The rising awareness of stem cell culture and its advanced application in life science is expected to fuel the growth of the segment.
Based on end user, the market is segmented into biotechnology and pharmaceutical industries, academic & research laboratories, and others. The biotechnology and pharmaceutical industries segment dominates the market. Factors such as increasing regulatory approvals for vaccines, rise in the use of cell culture consumables in research activities, and a surge in clinical research spending in developed as well as developing economies propel the growth of the segment.
The academic & research laboratories segment is expected to account for a significant share of the market over the forecast period. The rise in applications of these products in research studies globally boosts the segment growth.
On the basis of region, the global market is segmented into North America, Europe, Asia Pacific, and the rest of the world.
North America Cell Culture Media Market Size, 2024 (USD Billion)
To get more information on the regional analysis of this market, Download Free sample
The market size in North America stood at USD 1.20 billion in 2024. A major factor driving the growth of the market in this region is increasing spending on R&D activities by major players in the biopharmaceutical market. Furthermore, increasing efforts of key companies to expand their production capacity in the region also drive the growth of the market.
The increasing demand for viral vectors for gene therapy and the strategic developments done by key industry players in Europe augment the growth of the market.
Asia Pacific is projected to record the highest CAGR over the forecast period. The increasing demand for life science research and the rapid development of biopharmaceuticals, oncology, and stem cell research are a few of the driving factors for the market in this region. Additionally, there is an increase in initiatives of key companies to fulfil the rapidly growing demand for high quality culture media for various pharmaceutical and biotechnological processes.
Strong Product Portfolios of Thermo Fisher Scientific and Danaher Led to Their Dominance
The global market is consolidated and the major players account for a dominant share. Thermo Fisher Scientific and Danaher together accounted for major cell culture media market share in 2024. The dominance of these companies is attributed to the strong distribution network and their continuous efforts to launch new products in the market. Furthermore, strategic decisions such as mergers, acquisitions and expansion of manufacturing sites are also important factors leading these players to strengthen their market position.
Other prominent players such as FUJIFILM Irvine Scientific, Inc., BD (Becton, Dickinson and Company), Sartorius AG, and Corning Incorporated are focused on increasing their R&D activities to secure a significant position in the market.
The global cell culture media market research report provides a detailed analysis of the market. It focuses on key aspects such as new product launches, advantages of chemically defined media over other types, recent research and development activities, key market trends, and the impact of COVID-19 on the market. In addition to the factors mentioned above, it encompasses several factors that have contributed to the growth of the global market in recent years.
To gain extensive insights into the market, Download for Customization
|
ATTRIBUTE |
DETAILS |
|
Study Period |
2019-2032 |
|
Base Year |
2024 |
|
Forecast Period |
2025-2032 |
|
Historical Period |
2019-2023 |
|
Growth Rate |
CAGR of 13.6% from 2025-2032 |
|
Unit |
Value (USD billion) |
|
Segmentation |
By Type
|
|
By Application
|
|
|
By End User
|
|
|
By Region
|
Fortune Business Insights says that the global market size was USD 2.75 billion in 2024 and is projected to reach USD 7.37 billion by 2032.
In 2024, the North American market stood at USD 1.20 billion.
Registering a CAGR of 13.6%, the market will exhibit steady growth over the forecast period (2025-2032).
The classical media segment is expected to lead this market during the forecast period.
Increasing production of vaccines, rising research & development funding, and technological advancements in cell culture techniques are the major factors driving the growth of the market.
Thermo Fisher Scientific Inc., Merck KGaA, and Danaher are some of the major players in the global market.
North America dominated the market in terms of share in 2023.
Related Reports
Get In Touch With Us
US +1 833 909 2966 ( Toll Free )